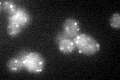
YMR204C

View description
Peripheral membrane protein of peroxisomes involved in peroxisomal inheritance; recruitment to peroxisomes is mediated by interaction with Pex3p at the peroxisomal membrane
Localization:
Intensity:
Fold change:
Significance:
-
C’ GFP library in SD

punctate21.7 -
N' NOP1pr-GFP in SD

punctate27.1746 -
N' TEF2pr-mCherry in SD

punctate12.6834 -
N' NATIVEpr-GFP in SD

punctate22.8624 -
N' TEF2pr-VC and Cyto-VN in SD

below threshold26.2454 -
C’ GFP library in SD+DTT
punctate19.90.91No -
C’ GFP library in SD+H2O2

punctate20.180.93No -
C’ GFP library in Starvation Media

punctate17.230.79Yes -
C’ GFP library on the background of Pup2-DaMP

punctate -
C’ GFP library on the background of CCT mutant

punctate19.90760.917155No
